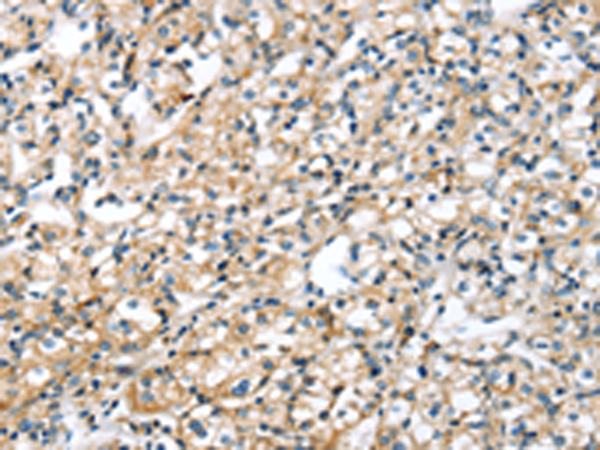

|
Background: |
SRPX gene also designated ETX1, resides within this region and is deleted in XLRP patients. There are at least two splice variants of SRPX, one of which contains a thirty amino acid signal peptide. Both variants contain three complement control protein domains, a hydrophobic region for membrane anchorage, and a cytoplasmic carboxy terminus. SRPX is expressed in retina and heart. SRPX is highly homologous to the drs (downregulated by v-src) human homolog, which suggests a role for SRPX as a tumor suppressor. |
|
Applications: |
ELISA, WB, IHC |
|
Name of antibody: |
SRPX |
|
Immunogen: |
Fusion protein of human SRPX |
|
Full name: |
sushi-repeat containing protein, X-linked |
|
Synonyms: |
DRS; ETX1; SRPX1; HEL-S-83p |
|
SwissProt: |
P78539 |
|
ELISA Recommended dilution: |
2000-10000 |
|
IHC positive control: |
Human prostate cancer and Human brain |
|
IHC Recommend dilution: |
25-100 |
|
WB Predicted band size: |
52 kDa |
|
WB Positive control: |
293T cells |
|
WB Recommended dilution: |
1000-5000 |
購物車
幫助
021-54845833/15800441009
